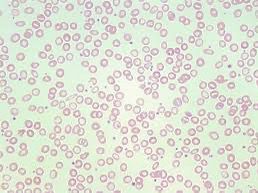
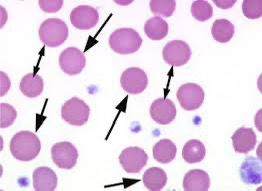
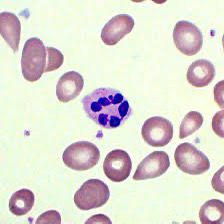

Hello,
Dr. BatmanPicture MCQ's


Hello Doctor, Welcome!
×

Profile

Name: Batman
Email: batman@gotham.com
MEDICINE
(Total Questions - 19)Q.1. What's the ECG finding?

Correct Answer : D
Q.2. Read the ECG

Correct Answer : A
Q.3. What's the diagnosis from the ECG?

Correct Answer : C
Q.4. What's the CXR finding?

Correct Answer : D
Q.5. What's the CXR finding?

Correct Answer : C
Q.6. What's the CXR finding?

Correct Answer : A
Q.7. What's the finding on the X ray?

Correct Answer : C
Q.8. What's the X ray finding?

Correct Answer : C
Q.9. What's the finding?
Correct Answer : A
Q.10. What's the finding?
Correct Answer : B
Q.11. What's the finding?
Correct Answer : D
Q.12. What's the finding?

Correct Answer : B
Q.13. What's the finding?

Correct Answer : B
Q.14. What's the finding?

Correct Answer : B
Q.15. What's the finding?

Correct Answer : C
Q.16. What's the finding?

Correct Answer : A
Q.17. What's the diagnosis?

Correct Answer : C
Q.18. What's the finding on CXR?

Correct Answer : B
Q.19. What's the CXR finding?

Correct Answer : A
Choose a Question
×
Trial Access Limit Reached
You’ve reached the limit of free content. Subscribe to continue learning without restrictions.